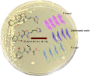

Search results
Search for "amino acids" in Full Text gives 548 result(s) in Beilstein Journal of Organic Chemistry. Showing first 200.
The role of spacer length and flexibility in peptide self-assembly
Beilstein J. Org. Chem. 2026, 22, 986–996, doi:10.3762/bjoc.22.77

- deprotection step using a solution of 8% piperidine (DMF, 2.1 mL) for 80 s at 110 °C. The amino acids (0.5 M in DMF, 1.0 mL), DIC (0.75 M in DMF, 1.0 mL) and Oxyma Pure (0.26 M in DMF, 1.5 mL) were added to the resin and the solution was heated to 105 °C for 60 s and held at that temperature for 30 s. The
Chiral cyclopropenimine-catalyzed enantioselective Michael reactions of phenol and benzofuran-derived α,β-unsaturated pyrazolamides with benzophenone-imine of glycine esters
Beilstein J. Org. Chem. 2026, 22, 888–896, doi:10.3762/bjoc.22.69
- catalyst [7][8]. Due to the importance of unnatural amino acids in the development of new medicines [9], we want to introduce phenol and benzofuran motifs to glutamic acids. For our continuous interest on the synthesis of chiral 3-substituted glutamic and pyroglutamic acids, herein, we present Michael
Site-specific labelling of native peptides and proteins: chemical and enzymatic strategies
Beilstein J. Org. Chem. 2026, 22, 857–881, doi:10.3762/bjoc.22.67

- , such as an epoxide, sulfonate ester or ester, enables targeted covalent modification of amino acids [105][106][107]. In addition to the choice of electrophiles, selectivity can be refined by tuning the length and flexibility of the linker, which controls the spatial proximity of the reactive groups
Synthesis and structural elucidation of a novel bis-spirooxindole from isatin and ethylenediamine
Beilstein J. Org. Chem. 2026, 22, 813–820, doi:10.3762/bjoc.22.63
- complexity and, in some cases, unexpected reaction outcomes. In reactions involving amino acids or diamines, the coexistence of multiple nucleophilic and electrophilic sites can give rise to competing pathways and polycyclic architectures. A well-documented example is the condensation of isatin (1) with ʟ
Synthesis of heterocycles based on azomethine ylides from α-amino acids (or amines) and carbonyl compounds
Beilstein J. Org. Chem. 2026, 22, 705–741, doi:10.3762/bjoc.22.55
- derivatives with multiple chiral centers under high regio- and stereocontrol. Currently, strategies using azomethine ylides based on imino esters or α-amino acids with a variety of cyclic and acyclic carbonyl compounds dominate. Enantioselective (3 + 2) cycloaddition reactions of azomethine ylides obtained
- from imino esters, catalyzed by chiral Cu(I,II) and Ag(I) complexes, are widely used. Reactions using α-amino acids proceed, in most cases, without the use of catalysts, with high yields and high stereoselectivity. Electrophilic alkenes of various structures, (hetero)aromatic olefins and benzofulvenes
- , cyclic and acyclic unsaturated substrates, and fullerenes are useful dipolarophiles. This reaction method allows for the single-step creation of a wide variety of complex polyheterocyclic systems that may be useful for practical applications. Keywords: alkenes; α-amino acids; azomethine ylides; carbonyl
Molecular tweezer–peptide conjugates disrupt the protein–protein interaction between survivin and histone H3 essential in mitosis
Beilstein J. Org. Chem. 2026, 22, 557–567, doi:10.3762/bjoc.22.41
- with well-defined localization on the survivin surface, all other amino acids are disordered [8]. This arrangement is stabilized by electrostatic interactions between histone H3’s phosphothreonine (pT) and basic residues on the core of the BIR domain as well as various basic residues of survivin’s α
- attached phosph(on)ate anions as powerful new hosts for the amino acids lysine and arginine. In the recent past, we demonstrated that the affinity and selectivity of our lysine-selective molecular tweezers could be improved by attaching natural peptide recognition elements. This could be documented in
- would allow a strong inclusion of a nearby R/K residue on survivin into the tweezer cavity. In fact five sterically well-accessible basic amino acids are located nearby in the survivin α-helix; their side chains point into the direction of the H3 binding site, ideally suited to accommodate the attached
Structural reassignment of compound 968, an allosteric glutaminase inhibitor
Beilstein J. Org. Chem. 2026, 22, 455–460, doi:10.3762/bjoc.22.33
- . Glutaminases catalyze the hydrolysis of glutamine to glutamate, which supports the biosynthesis of amino acids, lipids, and glutathione and can also be oxidatively deaminated to α-ketoglutarate and enter the citric acid cycle. The “glutamine addiction” of cancer cells has made glutaminase an attractive
Synthesis and anti-cancer activity of naphthalimide–organylselanyl conjugates
Beilstein J. Org. Chem. 2026, 22, 416–435, doi:10.3762/bjoc.22.29

- regions indicate more electronegative areas. For both compounds 7 and 8, the oxygen atoms exhibit the highest electronegativity, indicating potential nucleophilicity and the ability to readily participate in hydrogen bonding with amino acids through non-covalent interactions. Overall, MEP mapping reveals
Design, synthesis and biological evaluation of 2,5-diaryloxazolo[4,5-d]pyrimidin-7-ylamines as selective cytotoxic agents against HeLa cells
Beilstein J. Org. Chem. 2026, 22, 390–398, doi:10.3762/bjoc.22.27
- lone electron pair at the nitrogen atoms and protonated amino acids of proteins. However, oxazolo[5,4-d]pyrimidine forms more stable complexes, which is in good agreement with in vitro studies [10]. We have already shown the anticancer potential of 7-N-derivatives of 2,5-diaryl[1,3]oxazolo[4,5-d
Spirobarbiturates with a pyrrolizidine moiety: synthesis, structure and biological evaluation
Beilstein J. Org. Chem. 2026, 22, 274–288, doi:10.3762/bjoc.22.20
- azabicyclo[3.1.0]hexane and cyclopropa[a]pyrrolizine moieties can be synthesized via 1,3-dipolar cycloaddition between cyclopropene derivatives and azomethine ylides generated in situ from alloxan and α-amino acids [43]. In [43], a mechanism was proposed for the formation of azomethine ylides from alloxan
- and α-amino acids, which includes a stage of decarboxylation of the intermediate lactone. It is worth noting that generating azomethine ylides via decarboxylation of α-amino acid derivatives is a common practice in synthetic chemistry [44][45][46]. It was shown in our recent works that spirocyclopropa
- alloxan and α-amino acids) reacted with N-methylmaleimide was published by Ronald Grigg’s group in 1994 (Scheme 3) [52]. The authors reported the synthesis of spirobarbiturates containing various substituents: R’ = iPr (67%), Bn (61%), and Ph (66%). In this work, which is a continuation of studies on the
Conformational analysis of difluoromethylornithine: factors influencing its gas-phase and bioactive conformations
Beilstein J. Org. Chem. 2026, 22, 237–243, doi:10.3762/bjoc.22.17

- . This is consistent with the relative strength of hydrogen bonds (5–40 kcal mol−1) compared with typical hyperconjugative interactions [20]. Finally, because neutral amino acids dominate in the gas phase whereas zwitterions prevail in solution [21][22][23][24], the zwitterionic form of DFMO was examined
Highly electrophilic, gem- and spiro-activated trichloromethylnitrocyclopropanes: synthesis and structure
Beilstein J. Org. Chem. 2026, 22, 123–130, doi:10.3762/bjoc.22.5
- carboxylic acids [4]. The trichloromethyl group is a convenient precursor of the carboxylic function, which determines their use in the synthesis of α-amino acids [5]. A number of natural trichloromethyl-containing compounds are metabolites of symbionts of marine sponges – cyanobacteria [6][7][8] – and have
Advances in Zr-mediated radical transformations and applications to total synthesis
Beilstein J. Org. Chem. 2026, 22, 71–87, doi:10.3762/bjoc.22.3
- ). The developed dimerization protocol proved scalable to 100 g scale, affording 40 g of the desired dimer 61b in 47% yield. Subsequent removal of the two Boc groups with TMSI, followed by HATU-mediated amide coupling with various amino acids 65–67, furnished the diketopiperazine precursors 68–70
Recent advancements in the synthesis of Veratrum alkaloids
Beilstein J. Org. Chem. 2025, 21, 2657–2693, doi:10.3762/bjoc.21.206

- alkaloids belong to the class of steroid alkaloids and are pseudoalkaloids, as they emerge biogenetically from steroidal biosynthesis via cholesterol and not, as usual for alkaloids, from amino acids [1]. For synthetic chemists, this combines challenges for steroid and alkaloid total synthesis and poses
The high potential of methyl laurate as a recyclable competitor to conventional toxic solvents in [3 + 2] cycloaddition reactions
Beilstein J. Org. Chem. 2025, 21, 2389–2415, doi:10.3762/bjoc.21.184
- consisting of a combination of isoxazolidine rings [36][37][38][39][40][41]. It has been demonstrated that such cycloaddition reactions are also employed in the efficient preparation of biologically active molecules, including nucleosides, β-lactam class antibiotics, peptides, and amino acids, as well as
Enantioselective radical chemistry: a bright future ahead
Beilstein J. Org. Chem. 2025, 21, 2283–2296, doi:10.3762/bjoc.21.174
- cross-electrophile coupling of alkyl halides and nitroalkanes [76]. Yang and co-workers reported photoenzymatic asymmetric C(sp3)–C(sp3) oxidative cross-couplings between organoboron reagents and amino acids (Scheme 9) [37]. The authors used a synergistic system consisting of an engineered threonine
- aldolase, a photoredox catalyst, and an oxidizing agent. With this catalytic system, they were able to accomplish the C–H functionalization of glycine and α-branched amino acids, obtaining α-tri- and tetrasubstituted amino acids with moderate to good yields, good diastereoselectivity, and high
- )–C(sp3) coupling reactions between organoboron compounds and amino acids. Electrochemical α-alkenylation reactions of 2-acylimidazoles catalyzed by a chiral-at-rhodium Lewis acid. Regio- and enantioselective electrochemical reactions of silyl polyenolates catalyzed by a chiral nickel catalyst.
Research towards selective inhibition of the CLK3 kinase
Beilstein J. Org. Chem. 2025, 21, 2250–2259, doi:10.3762/bjoc.21.172
- of the Targets Our study started by a detailed analysis of the sequence of amino acids in CLK3 compared to the three other CLKs. There are several differences but one appeared very significant (Figure 1A): CLK3 has a polar lysine in position 241 while the other CLKs have a nonpolar leucine. Further
- present in DYRK kinases. Nevertheless, by highlighting the role of the lysine 241, the present work paves the way towards the long-term goal of getting more potent and selective inhibitors of this understudied CLK3 kinase. A) Sequence of amino acids in CLK3 as compared to the three other CLKs; B
Rhodium-catalysed connective synthesis of diverse reactive probes bearing S(VI) electrophilic warheads
Beilstein J. Org. Chem. 2025, 21, 1924–1931, doi:10.3762/bjoc.21.150
- amino acids [8][9][10]. Sets of reactive probes are generally prepared using robust reactions, most usually amide formation, chosen from the toolkit that currently dominates medicinal chemistry [11] which may, in turn, limit probe structural diversity. We have developed a unified connective approach for
Systematic pore lipophilization to enhance the efficiency of an amine-based MOF catalyst in the solvent-free Knoevenagel reaction
Beilstein J. Org. Chem. 2025, 21, 1854–1863, doi:10.3762/bjoc.21.144

- pharmaceutical and agrochemical industries [38][39]. Various types of catalysts are used to enhance the efficiency and selectivity of the Knoevenagel reaction, including Lewis acids, ureas/ thioureas, amino acids, and bases such as alkali metal hydroxides, alkali metal alkoxide, amines, etc. [37][40][41][42][43
Photoswitches beyond azobenzene: a beginner’s guide
Beilstein J. Org. Chem. 2025, 21, 1808–1853, doi:10.3762/bjoc.21.143

Research progress on calixarene/pillararene-based controlled drug release systems
Beilstein J. Org. Chem. 2025, 21, 1757–1785, doi:10.3762/bjoc.21.139

- mechanisms that will be detailed in this article, researchers have made progress in the transport of amino acids and molecular peptides across membranes using macrocycles in recent years [35][36][37]. These works have paved the way for the potential application of remote-controlled membrane transport
- drug design and therapeutic strategies. Notably, PA derivatives also exhibit specificity in recognizing important molecules in biological processes, such as acetylcholine [80], amino acids [81], doxorubicin (DOX) [82] and antibiotics [83], etc. Among the many derivatives, water-soluble pillar[5]arene
N-Salicyl-amino acid derivatives with antiparasitic activity from Pseudomonas sp. UIAU-6B
Beilstein J. Org. Chem. 2025, 21, 1388–1396, doi:10.3762/bjoc.21.103

- human system. In this study, we isolated two previously undescribed N-salicyl-amino acids as natural products (1 and 2) and other two new derivatives (3 and 4) from the organic extract of a culture broth in a modified starch–glucose–glycerol (SGG) medium of Pseudomonas sp. UIAU-6B. The structure of the
Oxetanes: formation, reactivity and total syntheses of natural products
Beilstein J. Org. Chem. 2025, 21, 1324–1373, doi:10.3762/bjoc.21.101
- co-workers reported an unprecedented synthesis of 3-aryl-3-aminooxetanes 156 from amino acids 155 utilising a combination of photoredox and nickel cross-coupling catalysis (Scheme 39) [90]. The reaction uses low catalyst loadings, gives moderate to excellent yields and tolerates various functional
A versatile route towards 6-arylpipecolic acids
Beilstein J. Org. Chem. 2025, 21, 1104–1115, doi:10.3762/bjoc.21.88
- accordance with coupling constants and resulting dihedral angles. Keywords: conformational restraints; dihedral angle NMR; half-chair conformation; modified amino acids; pipecolic acid; stereoselective hydrogenation; Suzuki–Miyaura cross-coupling; Introduction Non-proteinogenic amino acids play an
- important role as building blocks for peptide synthesis [1][2][3][4][5], as organocatalysts [6][7][8][9][10] and as enzyme inhibitors [4][11][12][13]. The incorporation of such amino acids into peptides can, for example, influence peptide conformation, the binding affinity to receptors [14], as well as
- pharmacokinetics [15][16], stability against degradation [17] and general stability [10][18] of the peptide [19]. One of those amino acids is pipecolic acid [20][21], a homolog of proline with a six-membered piperidine ring. Pipecolic acid has similar features as proline in regard to its rigid nature and turn
Supramolecular assembly of hypervalent iodine macrocycles and alkali metals
Beilstein J. Org. Chem. 2025, 21, 1095–1103, doi:10.3762/bjoc.21.87

- projecting outward denoted by an asterisk. Furthermore, the resulting crystal structure reveals that 1 is also a distorted planar macrocyclic system consisting of the amino acids carbonyl oxygens facing inside the ring. All three benzyl groups are located above a single plane (more figures are provided in